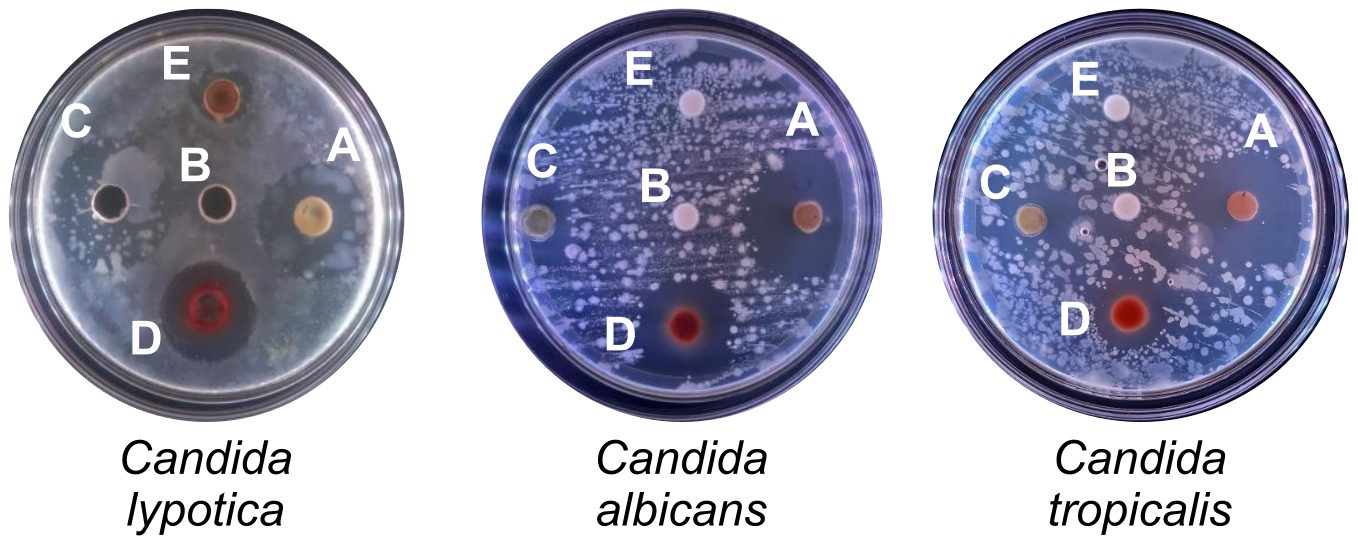

RESEARCH ARTICLE
Evaluation of Antimicrobial Properties of Passiflora foetida Root Extract Sourced from Rehabilitated Coal Mining Sites in East Kalimantan
Academic Editor: Khalid Abdelsamea Mohamedahmed
Sciences of Pharmacy|Vol. 4, Issue 4, pp. 278-285 (2025)
Received
Aug 27, 2025Revised
Sep 27, 2025Accepted
Oct 7, 2025Published
Nov 10, 2025
Abstract
Introduction
Reclamation of former coal mining land poses a significant environmental challenge. One of the approaches used is revegetation with cover crops. The function of cover crops is to improve post-mining soil conditions before planting with timber species (1, 2). Cover crops can reduce soil erosion, enhance nutrient content, and increase the productivity of post-mining land. Cover crops have strong regenerative abilities, grow rapidly, and possess roots capable of forming mutualistic symbioses with various fungi and bacteria. These plants can also grow year-round (3, 4). Rambusa, or Passiflora foetida, is a commonly employed cover crop. It is a climbing liana that spreads and grows along shrubs and roadsides (4).
The harsh habitat of the rambusa plant enables its roots to harbor unique bioactive substances, in contrast to rambusa plants thriving in fertile soils. The capacity of rambusa roots to endure severe post-mining land conditions renders them a valuable source of antioxidant bioactive chemicals, holding significant promise as raw materials for pharmaceutical research (5). Plants synthesize antioxidant chemicals to safeguard themselves from external and internal stressors. Numerous studies have shown that, to acclimate to severe settings, plants secrete specific bioactive chemicals in greater quantities to mitigate environmental stress (5).
Globally, increasing antimicrobial resistance is a major health concern because it threatens the effectiveness of existing antibiotics and antifungals. The World Health Organization identifies antimicrobial resistance as a leading global health threat. Recent years have seen a rise in antimicrobial resistance, which is projected to result in 10 million deaths annually by 2050 (6). The swift rise of multidrug-resistant pathogens, alongside the restricted advancement of new synthetic drugs, highlights the pressing need to investigate alternative therapeutic sources. Medicinal plants, particularly those capable of thriving in extreme environments, possess unique bioactive compounds that exhibit antimicrobial properties. This study examines the roots of P. foetida from former coal mine land as a potential source of unique antimicrobial metabolites, offering opportunities for the development of effective phytopharmaceutical agents against resistant microorganisms.
The rambusa plant has been conventionally employed for its leaves, fruits, and stems, which demonstrate antibacterial, larvicidal, antioxidant, and anticholesterol properties attributed to phytochemicals including alkaloids, flavonoids, polyphenols, and steroids (7-13). Recent studies have reported that the root extract of cover crop Rambusa grown on reclaimed post-mining land contains higher levels of antioxidant activity and bioactive compounds, particularly steroids, flavonoids, phenolics, and triterpenoids, compared to those grown in fertile soils (2). This advantage is likely due to the extreme environmental conditions influencing the plant’s metabolic profile (2). In line with previous findings, these bioactive compounds also demonstrate antibacterial and antifungal potential. However, research on the root-derived bioactives of rambusa, particularly from plants growing in reclaimed mining soils, remains limited.
This study sought to evaluate the antibacterial and antifungal characteristics of P. foetida root extract obtained from a reclaimed coal mining site, focusing on its bioactive potential as a viable phytopharmaceutical source. The samples will be extracted utilizing three different solvents: n-hexane will be used for non-polar bioactive molecules, ethyl acetate for semi-polar molecules, and ethanol for polar molecules. This methodology seeks to enable a comprehensive evaluation of all components and classifications of antibacterial bioactive substances. To assess the broad-spectrum antibacterial efficacy of the extract, representative strains of both Gram-negative and Gram-positive bacteria were employed, reflecting both of the primary bacterial classifications. This study concentrated on fungal testing of both pathogenic and non-pathogenic Candida species. This approach allows for a clear assessment of the antifungal potential of P. foetida root extract, including its effectiveness against opportunistic fungi.
Experimental Section
Materials
Root specimens of P. foetida L. (Rambusa) employed in this research were gathered from the reclamation area of PT Ganda Alam Makmur coal mine, East Kalimantan. The Center for Standardization of Environmental and Forestry Instruments in Samboja, East Kalimantan, performed taxonomic identification of the plant material. The other materials were Mueller- Hinton Agar (MHA) (Thermo Fisher Scientific, UK), Sabouraud Dextrose Agar (SDA) (Thermo Fisher Scientific, UK), potato dextrose broth (PDB), nutrient broth (NB) (Thermo Fisher Scientific, UK), ethanol, n-hexane, ethyl acetate (Brataco®, PT. Brataco Chemical, Indonesia), distilled water (aquadest), DMSO 5% technical grade (CAS 67-68-5, Merck, Germany), Mg powder and HCl (Merck, Germany) for flavonoid tests, FeCl3 (Merck, Germany) for phenolic tests, reagents for the Dragendorff, Meyer, and Wagner tests, and reagents for the Lieberman-Burchard, three types of test bacterial cultures (Shigella dysenteriae, Streptococcus mutans, Cutibacterium acnes), three types of test fungi (Candida albicans, Candida tropicalis, Candida lipolytica), ciprofloxacin, and fluconazole.
Tools
Erlenmeyer flasks (Pyrex®), measuring cylinders (Herma), test tubes (Iwaki), petri dishes (Pyrex®), beaker glasses (Pyrex®), analytical balance (Radwag AS 220. R1), micropipettes (Eppendorf), vernier caliper, rotary evaporator (RE-1000 VN), laminar air flow cabinet, hot plate (Faithful), oven (Getra®), vortex mixer (DLAB MX-S), water bath (Memmert), porcelain crucibles (Pyrex®), incubator, Bunsen burner, inoculating loop, stirring rods, autoclave, maceration containers, glass funnel, Buchner funnel, separatory funnel, dropper pipettes, and test tube racks.
Rambusa Extraction
The roots of rambusa plants were cleansed and then air-dried for a duration of 10 days. The desiccated simplicia were weighed, pulverized with a blender, sieved through a 60-mesh sieve, and stored in a hermetically sealed container (14). Extraction was later performed using a single maceration procedure with three different solvents (ethanol, ethyl acetate, and n-hexane) representing polar, semi-polar, and non-polar solvents, respectively. This approach was intended to explore the bioactive comprehensively compounds present in the rambusa cover crop roots. The macerates obtained were filtered to separate the filtrate from the residue. Finally, evaporation was carried out to yield a pure filtrate free from solvent residues (15).
Phytochemical Screening
Phytochemical screening of the P. foetida root extract was performed to identify major classes of secondary metabolites. Alkaloid detection using Mayer, Dragendorff, and Wagner reagents yielded positive reactions, indicated by whitish-yellow, reddish-orange, and brown precipitates, respectively. Flavonoids were confirmed by the presence of red, yellow, or orange coloration upon the addition of magnesium powder and hydrochloric acid, whereas phenolics were identified through the FeCl₃ test, which produced a green to black coloration. Saponins were detected using the froth test, indicated by the formation of stable foam. Meanwhile, terpenoids and steroids were verified by the Liebermann–Burchard reaction, which produced red to purple coloration for terpenoids and blue to green coloration for steroids (16, 17).
Antibacterial Activity Assay
The Kirby–Bauer disc diffusion method was employed to assess the antibacterial efficacy (18). Three bacterial test cultures (S. dysenteriae, S. mutans, and C. acnes) were subcultured in nutrient broth (NB) prior to antibacterial activity testing. The bacterial suspensions were adjusted to a standard density corresponding to 0.5 McFarland (19). Each indicator strain culture, amounting to 25 μL, was inoculated into dishes using 25 mL of Mueller–Hinton Agar (MHA). Sterilized paper disks were infused with 10% extracts of rambusa cover crop roots and subsequently placed onto the inoculation substrate. The extracts were first dissolved in DMSO and then diluted with sterile distilled water to reach the final amount of 10 mL. The inhibitory zone widths were measured from three distinct orientations after the plates were incubated at 37 °C for 24 h. Ciprofloxacin (5 ppm) served as the positive control, while DMSO functioned as the negative control. The dimensions of the inhibition zones (after subtracting the diameter of the paper disk) were categorized based on their inhibitory efficacy as weak (0–3 mm), moderate (3–6 mm), strong (6–9 mm), and powerful (> 9 mm). (18).
Antifungal Activity Assay
The Kirby–Bauer disc diffusion method was employed to assess the antifungal efficacy (18). This study included three fungal test cultures: C. albicans, C. tropicalis, and C. lipolytica. The fungal strains were subcultured in potato dextrose broth (PDB) prior to testing. The fungal suspensions were adjusted to a standard density corresponding to 0.5 McFarland (19). An aliquot of 25 μL from each indicator strain was spread onto plates containing 25 mL of Sabouraud Dextrose Agar (SDA). Sterile paper disks were impregnated with extracts of rambusa cover crop roots 60% and placed on the inoculated media. The extracts were initially dissolved in DMSO and subsequently diluted with sterile distilled water to reach a final volume of 10 mL. The inhibitory zone widths were measured from three distinct orientations after the plates were incubated at 35 °C for 48 h. Fluconazole (5 ppm) served as the positive control, while DMSO was employed as the negative control (18). The dimensions of the inhibition zones (after subtracting the diameter of the paper disk) were classified into four categories: weak (0–3 mm), moderate (3–6 mm), strong (6–9 mm), and very strong (> 9 mm) (18, 20).
Interpretation of Results and Data Analysis
The measured parameter was the diameter of the inhibitory zones surrounding the disks containing the extract. The data are shown as the mean ± standard deviation of the inhibition zones for each concentration of extract. Qualitative analysis was performed in accordance with the standards set by the Clinical and Laboratory Standards Institute (CLSI) (18). The analysis was conducted based on these results. Data validation involved assessing normality via the Shapiro–Wilk test, subsequently doing a significance test utilizing one-way ANOVA with SPSS software version 26.0. Following the identification of a substantial difference (p < 0.05), the analysis utilized Tukey’s Honestly Significant Difference post-hoc test to evaluate the mean inhibition zones across several groups.
Results and Discussion
Rambusa Extraction
Prior to extraction, the rambusa roots were taxonomically identified at the Laboratory of BPSILHK Samboja, East Kalimantan. This identification was performed to confirm the species authenticity of the plant material used in the study and to ensure the accurate nomenclature of the samples. The results of the determination show that the plant used indeed has the characteristics of P. foetida L. with Test Result Certificate Number S.492/BPSILHK. SBJ/SBTU/SET.3.1/B/10/2024.
The extraction in this investigation was conducted utilizing the maceration method. This process entailed submerging plant samples in a solvent, creating an osmotic pressure gradient between the intracellular and extracellular environments, which weakened the cell walls and membranes, so enabling the release of secondary metabolites into the solvent. The extraction utilized 99% ethanol, which is widely regarded as a universal solvent with a polarity index of 5.2 (21). Due to its strong polarity, ethanol enhances the efficiency of extraction and allows more compounds to be dissolved. In principle, the more polar the solvent, the higher the yield of extracted compound from simplicia. Moreover, 99% ethanol contains less water than 70% ethanol, thereby reducing the risk of extract contamination (22).
The fractionation technique used in this study is liquid-liquid partitioning. Fractionation aims to segregate substances according to their polarity variations. Table 1 presents the outcomes of the fractionation of the ethanol extract from the rambusa root. Liquid-liquid partitioning is performed by shaking using a separatory funnel. The principle of separation in fractionation is based on differences in polarity and specific gravity between the two fractions. The liquid-liquid partitioning method was selected due to its straightforward implementation and efficiency in extracting compound components from the extract based on polarity. The nonpolar solvent used in this study was n-hexane, the semipolar solvent was ethyl acetate, and the polar solvent was ethanol (23). The fraction yield data indicated that the ethanol extract of rambusa root comprised a higher concentration of polar chemicals compared to semipolar and nonpolar components.
| Solvent | Extract weight (gram) | Fraction Weight (gram) | Yield (%) |
|---|---|---|---|
| n-Hexane | 11 | 0.34 | 3.09 |
| Ethyl Acetate | 11 | 1.08 | 9.8 |
| Ethanol | 11 | 3.21 | 29.18 |
Phytochemical Screening
Phytochemical screening serves as a preliminary analysis to provide an overview of the classes of compounds present in the plant samples under investigation (Pratiwi et al. , 2023). The screening results of the ethanol extract, n-hexane fraction, and ethyl acetate fraction of P. foetida roots revealed the presence of several groups of secondary metabolites, as presented in Table 2.
| Test | Reagan | Type of Extract | ||
|---|---|---|---|---|
| Ethanol | n-Hexane | Ethyl acetate | ||
| Alkaloid | Mayer | + | + | + |
| Dragendroff | + | + | + | |
| Wagner | + | + | + | |
| Flavonoid | Mg and Concentrated HCl | + | - | + |
| Fenolik | FeCl3 | + | - | + |
| Saponin | Aquadest | + | - | - |
| Terpenoid | Lieberman-Burchard | + | - | + |
| Steroid | Lieberman-Burchard | - | + | - |
Based on the results of the phytochemical screening, ethanol, ethyl acetate, and n-hexane extracts of P. foetida roots exhibited different profiles of bioactive compounds. These differences are attributed to the varying polarity of each solvent. The ethanol extract yielded the broadest spectrum of bioactive compounds, including flavonoids, terpenoids, alkaloids, and saponins, reflecting its ability to dissolve polar, semi-polar, and non-polar constituents. The semi-polar ethyl acetate fraction was able to extract alkaloids, flavonoids, steroids, terpenoids, phenolics, and saponins, whereas the non-polar n-hexane fraction was more selective, primarily isolating alkaloids and steroids.
In comparison, Emin Baby et al. (2010) reported the presence of carbohydrates, glycosides, phytosterols, flavonoids, and phenolic compounds in their study on the methanolic root extract of P. foetida obtained by Soxhlet extraction (24). However, as this study employed only a single polar solvent (methanol), the spectrum of bioactive compounds identified was more limited than that observed in the present study. This comparison highlights that the use of multiple solvents with varying polarity is more effective in revealing a broader spectrum of bioactive compounds than relying solely on a single polar solvent. Such an approach underscores the novelty of the present study in providing a more comprehensive profile of secondary metabolites from the roots of P. foetida.
Antibacterial Activity Assay
The well diffusion assay was employed to assess the antibacterial efficacy of the ethanol extract, the n-hexane fraction, and the ethyl acetate fraction of P. foetida L. roots against S. dysenteriae, S. mutans, and C. acnes. By employing solvents of different polarity levels polar, semipolar, and nonpolar it was possible to capture a broader spectrum of bioactive compounds and identify the extract or fraction with the strongest antibacterial properties. All tests were performed at a concentration of 10% for the ethanol extract, n-hexane fraction, ethyl acetate fraction. A single concentration was utilized for an initial comparison to assess the relative efficacy of each fraction against the target bacterium. The outcomes are shown in Figure 1.

Table 3 shows that the extract and fractions of P. foetida L. root displayed varying levels of antibacterial activity against S. dysenteriae, S. mutans, and C. acnes. The inhibition was more significant in Gram-positive bacteria (S. mutans and C. acnes) than in the Gram-negative species (S. dysenteriae). This variation is due to differences in cell wall composition, as Gram-positive bacteria possess a simpler peptidoglycan layer with relatively low lipid content. Conversely, Gram-negative bacteria have a complex, multilayered cell wall that includes an external membrane abundant in phospholipids and lipopolysaccharides, which function as protective barriers (25). The complex structure and higher lipid content of Gram-negative bacteria may limit the penetration of bioactive compounds from P. foetida, thereby reducing their antibacterial efficacy (26).
| Microorganism | extract/fractions | Average ofinhibition zone±SD | Inhibition zone response category |
|---|---|---|---|
| Shigella dysenteriae | n-Hexane fraction | 6.00 ± 0.00 | Moderate |
| Ethyl Acetate fraction | 12.96 ± 0.05 | Strong | |
| Ethanol extract | 8.83 ± 0.286 | Moderate | |
| Positive Control (Ciprofloxacin) | 24.00 ± 0.00 | Very strong | |
| Negative Control (DMSO) | 0.00 ± 0.00 | None | |
| Streptococcus mutans | n-Hexane fraction | 14 ± 0.17 | Strong |
| Ethyl Acetate fraction | 21 ± 0.05 | Very strong | |
| Ethanol extract | 16 ± 0.05 | Strong | |
| Positive Control (Ciprofloxacin) | 24.00 ± 0.00 | Very strong | |
| Negative Control (DMSO) | 0.00 ± 0.00 | None | |
| Cutibacterium acnes | n-Hexane fraction | 11.83 ± 0.28 | Strong |
| Ethyl Acetate fraction | 13.60 ± 0.17 | Strong | |
| Ethanol extract | 11.00 ± 0.00 | Strong | |
| Positive Control (Ciprofloxacin) | 17.00 ± 0.00 | Strong | |
| Negative Control (DMSO) | 0.00 ± 0.00 | None |
Ciprofloxacin was utilized as the positive control in this study due to its broad-spectrum activity, which enables it to inhibit Gram-negative as well as Gram-positive bacteria by targeting DNA gyrase (27). The negative control, DMSO, exhibited no bactericidal action. The results correspond with the conclusions of Yani et al. (2024), who established that DMSO did not inhibit bacterial growth owing to its absence of antibacterial characteristics (27).
The sizes of the inhibitory zones were assessed according to CLSI criteria, categorizing antibacterial activity as weak if < 5 mm, moderate at 5–10 mm, strong at 10–20 mm, and powerful if > 20 mm (18). The results underwent additional analysis via ANOVA, revealing substantial differences between approaches, which were further validated by Tukey’s HSD test. No significant differences were noted among treatment groups against C. acnes; however, the fraction made from ethyl acetate had the most pronounced biological inhibitory efficiency compared to the other fractions. This fraction also exhibited the strongest antibacterial potential against S. mutans, with an effect approaching that of the positive control. Although it was less than the positive control, the ethyl acetate fraction nevertheless demonstrated a comparatively high level of activity for S. dysenteriae. Given that they are easier to extract in semipolar solvents like ethyl acetate, these results imply that chemicals with intermediate polarity are probably the main sources of the plant's antibacterial activity. Its efficacy, however, was not greater than that of the positive control, suggesting that more research is required to identify the precise active ingredients and improve its antibacterial capabilities. Nevertheless, its effectiveness did not surpass that of the positive control, indicating that further studies are needed to isolate specific active compounds and enhance its antibacterial potential.
The fraction consisting of ethyl acetate showed the most potent antibacterial activity against all three species, surpassing both the ethanol extract and the n-hexane fraction. This higher potency is attributed to its semipolar nature, which enables the extraction of both polar and nonpolar compounds, including glycosides and aglycones with antibacterial properties (28). Unlike n-hexane, which mainly dissolves nonpolar metabolites, or ethanol, which extracts highly polar compounds such as carbohydrates and proteins with limited antibacterial relevance, the ethyl acetate fraction contains a broader range of bioactive secondary metabolites, including alkaloids, flavonoids, and terpenoids. Stronger inhibition zones are produced by the complementary mechanisms of these compounds, which include disrupting cell walls (alkaloids and phenolics), decreasing membrane permeability (saponins, steroids, and terpenoids), and blocking nucleic acid synthesis (flavonoids) (29, 30). Moreover, ethyl acetate fractionation serves as an initial purification step of the ethanol extract, removing non-active compounds like carbohydrates and other impurities, resulting in a more concentrated presence of active metabolites and thus the highest antibacterial effect (31).
Antifungal Activity Assay
In this study, antifungal fractions and extracts were more concentrated than antibacterial fractions and extracts. The concentration used as an antibacterial agent is 10%, while the concentration for antifungal is 60%. The structure of the fungal cell wall, which is made up of mannoprotein, β-glucan, and chitin, creates a complex protective layer that further prevents antimicrobial chemicals from penetrating, which explains the variation in concentration. Chitin and β-glucan give it mechanical strength, but the outer layer's mannoprotein prevents active substances from entering. A greater concentration of the extract is necessary to generate an inhibitory zone against fungal development in comparison to bacteria. The outcomes are shown in Figure 2 and Table 4.
| Microorganism | extract/fractions | Average of inhibitionzone±SD | Inhibition zone response category |
|---|---|---|---|
| Candida lypotica | n-Hexane fraction | 1.40 ± 0.07 | Weak |
| Ethyl Acetate fraction | 7.3 ± 0.05 | Moderate | |
| Ethanol extract | 6.3 ± 0.08 | Moderate | |
| Positive Control (Fluconazole) | 19.00 ± 0.00 | Strong | |
| Negative Control (DMSO) | 0.00 ± 0.00 | None | |
| Candida albicans | n-Hexane fraction | 6 ± 0.27 | Moderate |
| Ethyl Acetate fraction | 9 ± 0.00 | Moderate | |
| Ethanol extract | 10.4 ± 0.26 | Strong | |
| Positive Control (Fluconazole) | 20.00 ± 0.00 | Strong | |
| Negative Control (DMSO) | 0.00 ± 0.00 | None | |
| Candida tropicalis | n-Hexane fraction | 8.73 ± 0.28 | Moderate |
| Ethyl Acetate fraction | 19.00 ± 0.21 | Strong | |
| Ethanol extract | 20.00 ± 0.00 | Strong | |
| Positive Control (Fluconazole) | 20.00 ± 0.00 | Strong | |
| Negative Control (DMSO) | 0.00 ± 0.00 | None |
The research findings, represented as inhibition zone diameters, were statistically analyzed using ANOVA, followed by the Tukey HSD test. This study's results demonstrate that the ethyl acetate fraction and ethanol extract of rambusa cover crop roots exhibit notable antifungal activity against the three tested Candida species, with effectiveness varying significantly based on species type and solvent polarity. The antifungal activity observed through the inhibition zone diameters suggests that the active compounds contained in the extracts are either fungistatic or fungicidal. This pattern aligns with numerous reports stating that solvent polarity greatly influences the effectiveness of extracting antifungal compounds: semi-polar to polar solvents (for example, ethanol and ethyl acetate) tend to extract flavonoids, phenols, or tannins, which possess antifungal activity capable of disrupting the integrity of fungal cell membranes (32-36).
The most significant finding is the strong activity of the ethyl acetate fraction and ethanol extract against C. tropicalis, which even showed an inhibition zone comparable to the positive control fluconazole. This indicates that rambusa cover crop roots contain compounds that are highly potent and specific against this species. The variation in sensitivity among species is supported by research reporting that C. tropicalis often exhibits a different sensitivity profile compared to C. albicans and other non-albicans species, likely due to differences in cell wall permeability or expression of target proteins (37).
Ethyl acetate and ethanol fractions, which are recognized for their abundance of polar and semi-polar compounds, including polyphenols, flavonoids, and tannins, interact with components of the fungal cell membrane, particularly ergosterol, a critical structural part of fungal membranes. Alteration of the ergosterol structure leads to increased permeation of membranes, leakage of cellular components, and ultimately, the death of fungal cells. Additionally, some compounds in the ethyl acetate and ethanol fractions have also been reported to inhibit key enzymes involved in ergosterol biosynthesis, such as lanosterol demethylase, thereby enhancing their antifungal effects (35, 37, 38).
The ethyl acetate fraction yielded the most promising antibacterial and antifungal activities in the root extracts of P. foetida grown on coal reclamation land. It should be noted that ethyl acetate primarily extracts semipolar compounds. Several phytochemical studies on the Passiflora genus have identified specific metabolites such as vitexin, isovitexin, orientin, and isoorientin (flavonoid C-glycosides), as well as β-carboline alkaloids including harmine, harmane, and harmaline (39-41). These compounds have been widely reported to exhibit antibacterial and antifungal activities. Although there are no direct reports confirming that the ethyl acetate fraction of P. foetida roots contains all of these compounds simultaneously, existing literature strongly supports the likelihood of their presence in this fraction, considering their semipolar characteristics.
It should be noted that soil conditions such as nutrient availability, the presence of heavy metals, and pH often significantly affect the concentration and diversity of secondary metabolites in plants. Some studies have shown striking variations in flavonoid content in plants grown in habitats with different soil physicochemical properties (42). Similarly, plants grown in heavy metal-contaminated soil show changes in the biosynthesis of compounds such as phenolics, flavonoids, and terpenoids (43). Thus, the soil conditions where P. foetida grows on reclaimed coal mine land are very likely to be different from fertile soil, both in terms of heavy metal residues, low organic matter content, and affected pH. These factors can explain the differences in metabolite profiles and antimicrobial activity in P. foetida growing in reclaimed soil compared to those growing in fertile soil. The strong antimicrobial activity in this study aligns with previous findings reporting antibacterial activity from P. foetida root extracts grown in fertile soil (24).
Conclusion
This study revealed that root extracts of P. foetida from rehabilitated coal mining land possess considerable antibacterial efficacy against S. dysenteriae, S. mutans, and C. acnes, in addition to antifungal efficacy against C. albicans, C. tropicalis, and C. lipolytica. The ethyl acetate fraction demonstrated the most pronounced and comprehensive effects. The findings underscore the promise of P. foetida as a natural antibacterial agent; nevertheless, additional research is required to isolate active chemicals and validate their efficacy and safety in vivo.
Abbreviations
MHA = Mueller-Hinton Agar; SDA = Sabouraud Dextrose Agar; NB = Nutrient Broth; PDB: Potato Dextrose Broth; DMSO = Dimethyl Sulfoxide; SPSS = Statistical Package for the Social Sciences; CLSI = Clinical and Laboratory Standards Institute; ANOVA = Analysis of Variance; SD = Standard Deviation.
Declarations
Acknowledgment
The authors would like to express their gratitude to the Ministry of Education, Culture, Research, and Technology of Indonesia for funding this research through the Penelitian Dosen Pemula Afirmasi program (Contract No. 132/C3/DT.05.00/PL/2025). The authors also thank PT. Ganda Alam Makmur for granting permission to conduct sampling activities.
Conflict of Interest
The authors declare no conflict of interest.
Data Availability
The datasets generated during and/or analyzed during the current study are available from the corresponding author on reasonable request.
Ethics Statement
This research involved only plant material and in vitro assays; therefore, no ethical approval was required. Plant sampling was conducted with permission from PT. Ganda Alam Makmur, East Kalimantan, Indonesia.
Funding Information
The authors declare that this study received funding from the Ministry of Education, Culture, Research, and Technology of Indonesia under the Penelitian Dosen Pemula Afirmasi scheme (Contract No. 132/C3/DT.05.00/PL/2025).
References
- Tampubolon G, Mahbub ILM. Pemulihan kualitas tanah bekas tambang batubara melalui penanaman Desmodium ovalifolium. J Teknol Miner dan Batubara. 2020;16(1):39-45.
- KalTim D. Satu Data Kalimantan Timur: Data Pertambangan Provinsi KalTim. 2024.
- Yassir I, KB. Tanaman penutup tanah (cover crop) untuk reklamasi tambang batubara. Balikpapan: Balai Penelitian Teknologi Konservasi Sumber Daya Alam; 2014.
- Yassir I, SB. Jenis-jenis tumbuhan dari proses regenerasi alam di lahan bekas tambang batubara. Balikpapan: Balai Penelitian Teknologi Konservasi Sumber Daya Alam; 2014.
- Chen D, Mubeen B, Hasnain A, Rizwan M, Adrees M, Naqvi SAH, et al. Role of promising secondary metabolites to confer resistance against environmental stresses in crop plants: current scenario and future perspectives. Front Plant Sci. 2022;13(May):1-26.
- Spanhaak S, Havenaar R, Schaafsma G. The effect of consumption of milk fermented by Lactobacillus casei strain Shirota on the intestinal microflora and immune parameters in humans. Eur J Clin Nutr. 1998;52(12):899-907.
- Nishia WM, Indah WU, Nurazizah. Exploration of bioactive compounds of rambusa (Passiflora foetida L.) root extract from East Kalimantan coal reclamation land as antioxidant. J Kim Ris. 2024;9(2):135-43.
- Wardani YK, Elok KEB, Sucahyo S. Korelasi antara aktivitas antioksidan dengan kandungan senyawa fenolik dan lokasi tumbuh tanaman Celosia argentea Linn. Bioma Berk Ilm Biol. 2021;22(2):136-42.
- Wijayanti S, Heriani H, Mustamin F, Syuhada S. Antibacterial activity test of ethanol extract of rambusa leaves (Passiflora foetida L.) against Pseudomonas aeruginosa bacteria. J Borneo. 2022;2(3):21-7.
- Sari GNF, Puspitasari I. Aktivitas antibakteri dan bioautografi ekstrak daun rambusa (Passiflora foetida L) terhadap Pseudomonas aeruginosa-Klebsiella pneumoniae. Media Farm J Ilmu Farm. 2021;18(2):102-14.
- Wardani YK, Kristiani EBE, et al. Uji aktivitas antibakteri ekstrak etil asetat daun rambusa dan daun karamunting terhadap Streptococcus mutans. J Surya Med [Internet]. 2022;2(2):60-5.
- Gregorius O, Thobias HADR. Effectiveness test of rambusa (Passiflora foetida L.) fruit extract as a liquid anti-mosquito on the development vector of malaria mosquito (Anopheles sp.). Jambura Edu Biosf J. 2020;2(2):44-50.
- Skripsi T, Vito G, Pramana C. Pengaruh ekstrak buah rambusa (Passiflora foetida) terhadap pertumbuhan bakteri Streptococcus pyogenes. 2022.
- Kiko PT, Taurina W, Andrie M. Karakterisasi proses pembuatan simplisia daun sirih hijau (Piper betle) sebagai sediaan obat penyembuhan luka. Indones J Pharm Educ. 2023;3(1):16-25.
- Kemenkes. Farmakope Herbal Indonesia Edisi III. Kementerian Kesehatan RI; 2017.
- Wardhani RK, Pardede A. Analisa fitokimia dan aktivitas antioksidan ekstrak metanol batang, daun, kulit buah dan buah tanaman kelubut (Passiflora foetida). Dalt J Pendidik Kim dan Ilmu Kim. 2022;5(2):62.
- Peni Pindan N, Saleh CR, Magdaleni A. Uji fitokimia dan uji aktivitas antioksidan dan ekstrak fraksi n-heksana, etil asetat dan etanol sisa dari daun sungkai (Pernonema canescens Jack.) dengan metode DPPH. J At. 2021;6(1):22-7.
- Weinstein MP, Lewis JS. The Clinical and Laboratory Standards Institute subcommittee on antimicrobial susceptibility testing: background, organization, functions, and processes. J Clin Microbiol. 2020;58.
- Aviany HB, Pujiyanto DS. Analisis efektivitas probiotik di dalam produk kecantikan sebagai antibakteri terhadap Staphylococcus epidermidis. Berk Bioteknol. 2020;3(2):24-31.
- Ríos JL, Recio MC. Medicinal plants and antimicrobial activity. J Ethnopharmacol. 2005;100(1-2):80-4.
- Kumar A, Nirmal P, Kumar M, Jose A, Tomer V, Oz E, et al. Major phytochemicals: recent advances in health benefits and extraction method. Molecules. 2023;28(2):1-41.
- Rosa DY, Primiani CN, Bhagawan WS, Pujiati. Rendemen ekstrak etanol daun genitri (Elaeocarpus ganitrus) dari Magetan. Semin Nas Prodi Farm UNIPMA [Internet]. 2023;2023:146-53.
- Muhammad AA, Tatiana SW, Anna F. Uji aktivitas antibakteri ekstrak dan fraksi n-heksan, etil asetat, air kulit buah naga putih (Hylocereus undatus) terhadap Staphylococcus epidermidis ATCC 12238. OBAT J Ris Ilmu Farm dan Kesehat. 2024;2(4):41-56.
- Baby E, Balasubramaniam A, Manivannan R, Jose J, Senthilkumar N. Antibacterial activity of methanolic root extract of Passiflora foetida Linn. J Pharm Sci Res. 2010;2(1):38-40.
- Jawetz E, Melnick JL, Adelberg EA. Mikrobiologi Kedokteran. Vol XXII. Jakarta: Salemba Medika; 2001. 317 p.
- Khotimah K, Kusnadi J. Antibacterial activity of probiotic date fruit (Phoenix dactylifera L.) beverages using Lactobacillus plantarum and Lactobacillus casei. J Pangan Agroindustri. 2014;2(3):110-20.
- Yani RD, Hasanuddin S, Ode SL, Anggriani SF, Alani FW, Mega WP, et al. Uji aktivitas antibakteri ekstrak etanol akar enau (Arenga pinnata Merr.) terhadap Staphylococcus aureus dan Escherichia coli. J Pharm Mandala Waluya [Internet]. 2024;3(6):392-408.
- Monica S, Siska WT, Dwi SA. Uji aktivitas antibakteri ekstrak, fraksi n-heksan, fraksi etil asetat, fraksi air daun pegagan (Centella asiatica (L.) Urb) terhadap Escherichia coli ATCC 25922. Media Farm Indones. 2021;16(2):1683-92.
- Katja DG, Runtuwene MRJ, Koleangan HSJ, Sinaga JCE. Aktivitas antibakteri ekstrak dan fraksi kulit batang Chisocheton sp. (C.DC) Harms terhadap Pseudomonas aeruginosa secara in silico dan in vitro. Chem Prog. 2025;18(1):31-9.
- Harlita TD, Aina GQ, Kartini R. Aktivitas antibakteri kombinasi ekstrak etanol bawang Dayak (Eleutherine palmifolia (L.) Meer) dan jahe merah (Zingiber officinale Rosc var Rubrum) terhadap pertumbuhan Salmonella typhi. Sains Med. 2022;1(2):109-17.
- Ramadhani MA, Novema AP. Aktivitas antibakteri ekstrak kasar dan terpurifikasi daun cengkeh (Syzygium aromaticum) terhadap Escherichia coli dan Staphylococcus aureus. Borobudur Pharm Rev. 2022;2(1):8-14.
- Méndez D, Escalona-Arranz JC, Pérez EM, Foubert K, Matheeussen A, Tuenter E, et al. Antifungal activity of extracts, fractions, and constituents from Coccoloba cowellii leaves. Pharmaceuticals. 2021;14(9).
- Kebede B, Shibeshi W. In vitro antibacterial and antifungal activities of extracts and fractions of leaves of Ricinus communis Linn against selected pathogens. Vet Med Sci. 2022;8(4):1802-15.
- Listyaningrum A, Ponco RM, Wulandari D. Uji aktivitas antijamur fraksi n-heksana, etil asetat, dan air ekstrak metanol kulit batang jambu mete (Anacardium occidentale L.) terhadap Candida albicans ATCC 10231. J Kesehat Farmasi. 2023;(1):15-22.
- Peters BM, Ward RM, Rane HS, Lee SA, Noverr MC. Efficacy of ethanol against Candida albicans and Staphylococcus aureus polymicrobial biofilms. Antimicrob Agents Chemother. 2013;57(1):74-82.
- Syafruddin A, Jasmiadi. Uji aktivitas antifungi fraksi ekstrak etanol daging buah kecapi (Sandoricum koetjape Merr.) asal Kabupaten Pinrang terhadap Candida albicans. J Novem Med Farm. 2024;3(2):1-12.
- Doifode SA, Bhosle SS. Phytochemical screening and pharmacological evaluation of Passiflora foetida L. leaf extract found in the vicinity of Lonar Lake: a distinctive saline crater lake in India. 2025:1-19.
- Zhang L, Lin H, Liu W, Dai B, Yan L, Cao Y, et al. Antifungal activity of the ethanol extract from Flos Rosae Chinensis with activity against fluconazole-resistant clinical Candida. Evid Based Complement Altern Med. 2017;2017.
- Avula B, Wang YH, Rumalla CS, Smillie TJ. Simultaneous determination of alkaloids and flavonoids from aerial parts of Passiflora species and dietary supplements using UPLC-UV-MS and HPTLC. Nat Prod Commun. 2012;7(9):1177-80.
- Grice ID, Ferreira LA, Griffiths LR. Identification and simultaneous analysis of harmane, harmine, harmol, isovitexin, and vitexin in Passiflora incarnata extracts with a novel HPLC method. J Liq Chromatogr Relat Technol. 2006;24(16):2513-23.
- Gadioli IL, da Cunha MSB, de Carvalho MVO, Costa AMPL. A systematic review on phenolic compounds in Passiflora plants: Exploring biodiversity for food, nutrition, and popular medicine. Crit Rev Food Sci Nutr. 2018;58(5):785-807.
- Pant P, Pandey S, Dall’Acqua S. The influence of environmental conditions on secondary metabolites in medicinal plants: a literature review. Chem Biodivers. 2021;18(11).
- Asare MO, Száková J, Tlustoš P. The fate of secondary metabolites in plants growing on Cd-, As-, and Pb-contaminated soils — a comprehensive review. Environ Sci Pollut Res. 2023;30(5):11378-98.
